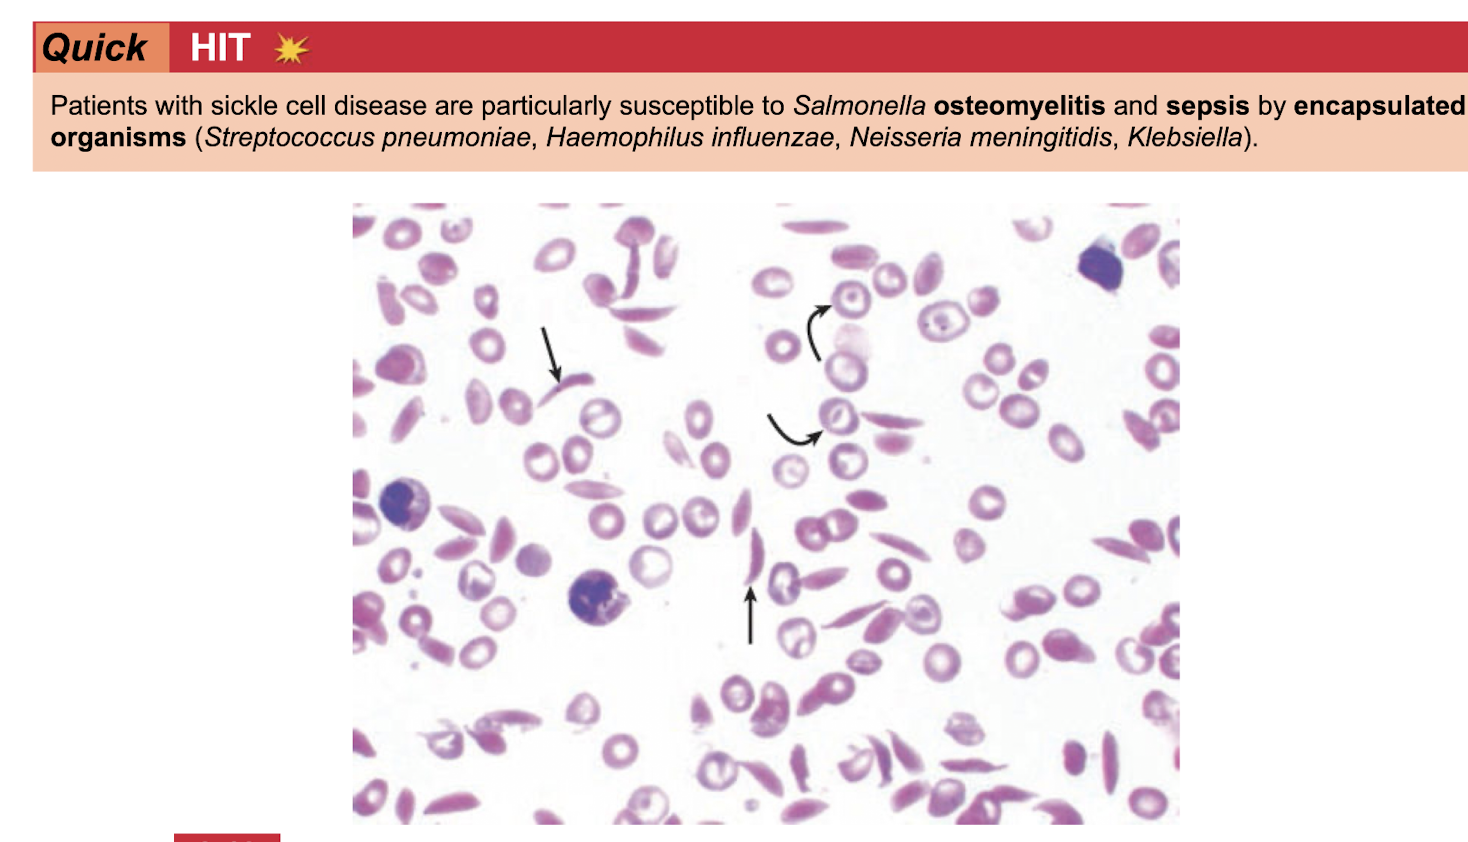
<p>Salmonella osteomyelitis&nbsp;</p><p class="p1">Sepsis by NSH + klebsiella (encasuplated)&nbsp;</p>
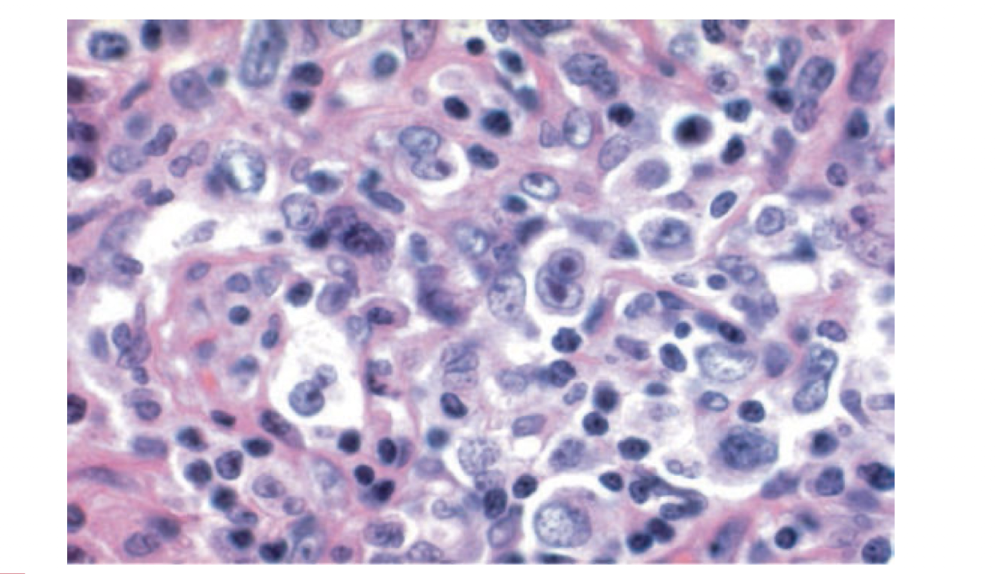
term image
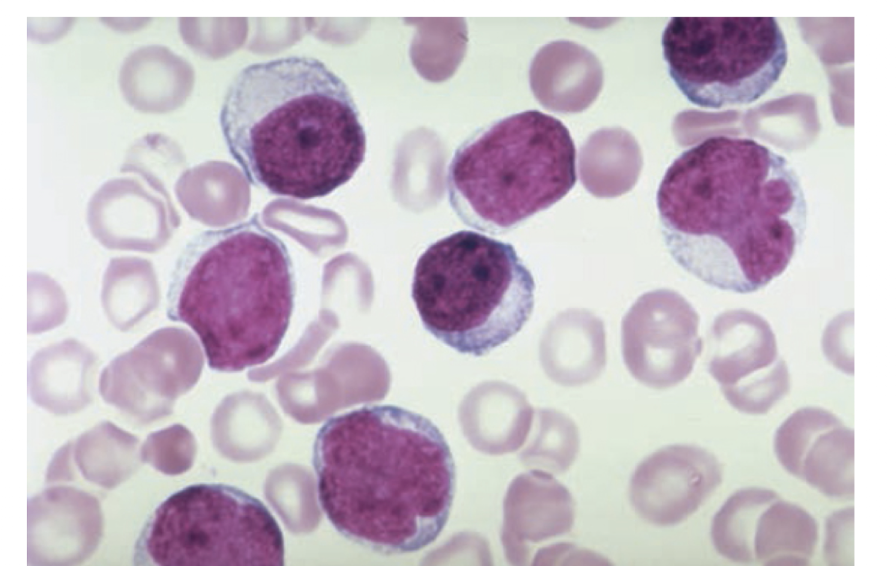
term image

1/109
Looks like no tags are added yet.
Name | Mastery | Learn | Test | Matching | Spaced | Call with Kai |
|---|
No analytics yet
Send a link to your students to track their progress
RBC Physiology
-RBCs serve to transport
-Normal Hgb ____ serves as
-Left shift vs Right shift DOC
-Circulating RBCs, myeloid cells and lymphoid cells all originate from
-RBCs become enucleated during

Next Step: If a patient presents with CO poisoning

CO poisoning includes signs of
mental status changes
cherry red lips
hypoxia despire normal pulse ox readings
Hgb-Ox disssociation curve
left shift
red shift

Normal Hgb concentrations and Hct

Micocytic anemia pneumonic

Classification of Anemias

Hemolytic Anemia
-defined by
-can be caused by
-SXS
-Workup
-Coombs Test
-Blood smear

Mean RBC lifespan is
Consider IDA in elderly patients caused by

IDA
-defined as
-results from
-SXS

IDA
-Workup
-Blood Smear
-Tx

Drug induced hemolytic anemia
-Pathophysiology
-Blood Smear
-Coombs Test
-Other Diagnostic Aids
-Treatment

Auto-Immune Hemolytic Anemia (AIHA)
-Pathophysiology
-Blood Smear
-Coombs Test
-Other Diagnostic Aids
-Treatment

Mechanical Hemolytic Anemia
-Pathophysiology
-Blood Smear
-Coombs Test
-Other Diagnostic Aids
-Treatment

Hereditary spherocytosis hemolytic anemia
-Pathophysiology
-Blood Smear
-Coombs Test
-Other Diagnostic Aids
-Treatment

G6PD hemolytic anemia
-Pathophysiology
-Blood Smear
-Coombs Test
-Other Diagnostic Aids
-Treatment

Labs
Serum Iron
Ferritin
TIBC (transferrin)
Iron: TIBC Ratio
Blood smear
Type:
IDA
Chronic Dz
Lead poisioning
Sideroblastic
Thalassemia

Lead Poisoning Anemia
-defined by
-similar presentation seen in
-SXS
-Workup
-Blood Smear

Folate deficiency is most common cause of
megaloblastic anemia
Folate Deficiency anemia
-SXS

Inadequate folate intake is seen with _____ and in the ____ because of poor nutrition
alcoholism and in the elderly
Vitamin B12 def anemia
-SXS

Inadequate B12 intake is usually only seen in
strict vegetarians/ vegans
Anemia of chronic disease
-defined by
-frequently assoicated with
-SXS
-Workup
-Blood smear
-TX

___caused by inadequate dietary intake develops ___ vs ____from inadequate intake

Aplastic Anemia
-Due to
-SXS
-Workup
-Tx

Aplastic anemia in Sickle cell patient is classically caused by

Sideroblastic anemia
-defined by
-can be a ___ or caused by ____
-Blood smear
-Tx
-Complications

Patients with alpha thalsaeemia minima usually have a
normal MCV
Thalassemia
-defined. by
-disease state arrises from
-normal Hgb

Types of thalassemias and characteristics

Alpha vs beta
-more prevalant in
-variants between

Thalassemia
-Workup
-Blood smear
-Tx
-Complications

Next Step: if microcytic anemia if found on blood smear

Heterozygous carriers of sickle cell defect (sickle cell trait) are
Presence of fetal hgb in newborns delays presentation of

Sickle cell disease
-___ cause Hgb S molecules to polymerize and distort RBCs into

Sickle Cell Disease
-Radiology
-Blood Smear
Radiology:
Codfish vertebrae
Lung infiltrates if acute chest syndrome
Blood smear:
Target cells
Nucleated RBCs
Deoxygenation of blood producing sickle cells

Sickle Cell Disease
-Crisis treatment
-To decrease frequency of crises
-Asplenia patients need
Sickle cell crisis treatment:
- hydration
-supplemental O2
-analgesics
To decrease frequency of crises
-hydroxyurea
Asplenic patients:
-pneumococcal vaccine reduced risk of infection in asplenic patients
-Give prophylactic penicillin until age 5 if no spleen

Patients with sickle cell disease are particularly susceptible to
Salmonella osteomyelitis
Sepsis by NSH + klebsiella (encasuplated)
Lymphopenia without Immune deficiency
-Def
-SXS
-Workup
-Tx

Eosinophilia
-Def
-SXS
-Workup
-Tx

Neutropenia
-def
-SXS
-Workup
-Tx

HSR reactions
-def
-Workup
-Tx

Types of HSR table

Anaphylaxsis
-Def
-SXS
-Workup
-Tx

Normal Clotting Functions: Platelets

Next Step: monitor heparin anticoagulation with
PTT
LWMH do NOT require
monitoring by PTT
Normal Clotting Function: Coagulation Cascade

Common Anticoagulant Drugs
Mechanism
Role
Adverse Effects
Drugs:
ASA
Thienopyridines (ex.clopidogrel, ticlopidine)
GP3b/2b inhibitors (abciximab, tirofiban, eptifibatide)
Adenosine reuptake inhibitors (dipyridamole)
Heparin
LWMH/ enoxaparin/dalteparin
Direct Thrombin inhibitors (apixaban, rivaroxaban)
Direct XA inhibitors (-ban)
Warfarin

Antithrombic drugs are used to ____; can affect ______

Next Step: Monitor warfarin anticoagulation with

Do not start warfarin therapy for _____ until _____ because _____

Thrombocytopenia
-Defined as
-may be caused by
-SXS
-Workup
-Blood smear

Causes of thrombocytopenia
pathology
Dx
Tx
Impaired production
drugs
infection
aplastic anemia
folate/vitamin B 12 def
alcohol
cirrhosis
abnormal pooling
HIT

Causes of thrombocytopenia
pathology
Dx
Tx
ITP
TTP-HUS
Antiphospholipid Syndrome

Causes of thrombocytopenia
pathology
Dx
Tx
HELLP syndrome

vWD
-def
-SXS
-workup
-Tx

Administration of FFP is indicated in patients with
VWF and Factor8 are the only clotting factors not synthesized eclusively by
patients using warfarin can present with clinical picture similar to that of

Vitamin K deficiency
-definition
-Vitamin K is required in
-SXS
-Workup
-Tx

Hemophilia
-definition of
-SXS
-Workup
-Tx
-Complications

Hemophiliacs tend not to develop significant bleeds unless they have

DIC
-def and pathophysiology
-SXS
Workup
-Blood smear
-Treatment
-Complications

Bleeding in DIC occurs because
bleeding in other clotting disorders occurs because

Sepsis
-Defined by
-Dx criteria for SIRS
-Common community acquired pathogens include
-Common nosocomial pathogens include
-SXS
-Workup
-Radiology
-Staph aureus is most common cause of sepsis in
-Tx
-Complication

Sepsis: Next Step: Do not start abx until after

Malaria
-def
-SXS
-workup
-blood smear
-tx

although rare in US, malaria is common in ___
travers should take _____

Infectious mononucleosis
-def
-transmitted by
-SXS
-Workup
-Blood smear
-Tx
-Complications

Symptoms of mono do not appear until

HIV infection has greatest prevlance in
transmission typically through

HIV
-defined by
-Viruses use
-Transmitted via

HIV
-Following acute infection, patients enter
-Late SXS

Next Step: although rate of HIV transmission through needle sticks is very low, prophylactic ______ should be started immediately if there is an appreciable risk of transmission
_____ tests should be performed _____ after exposure to determine if transmission occured
-Tx should be continued for ____

Opportunistic infections, Neoplasms and Complications seen in AIDS:
CD4 level when seen
SXS
Dx
Tx
HSV
Kaposi Sarcoma
Parasitic Diarrhea (isopora, strongyloides, cryptosporidum)
Wasting syndrome

Opportunistic infections, Neoplasms and Complications seen in AIDS:
CD4 level when seen
SXS
Dx
Tx
Coccidiodomycosis
AIDS dementia
Bacterial PNA (S. PNA, H.flu, Nocardia)

Opportunistic infections, Neoplasms and Complications seen in AIDS:
CD4 level when seen
SXS
Dx
Tx
Candida esophagitis
Cervical Cancer
PJP

Opportunistic infections, Neoplasms and Complications seen in AIDS:
CD4 level when seen
SXS
Dx
Tx
TB
Histo
Cerebral Toxo

Opportunistic infections, Neoplasms and Complications seen in AIDS:
CD4 level when seen
SXS
Dx
Tx
Lymphoma (CNS or non Hodgkin)
PML/JC virus
Cryptococcal meningitis

Opportunistic infections, Neoplasms and Complications seen in AIDS:
CD4 level when seen
SXS
Dx
Tx
CMV
Mycobacterium avium complex

HIV
-W/U
1. ELIZA
2. Repeat ELIZA if positive
3. Western blot to r/o false positive
4. Viral load and CD4 count to track extent of disease progression

It may take up to _____ for HIV abs to appear in the serum
6 months
Serologic profile of HIV

HIV
-Treatment
ART should be initated for all HIV infected patients, regardless of
Utility of starting ART in acute infection is
Common initial HAART regimens
Compliance with therapy is
Indications for changing ART include
Abx prophylaxis for opportunistic infections
close following of serology is important for
Pregnant mothers with HIV
-Complications

Mother to infant transmission of HIV is
rare when viral load <1000
ART for HIV
-Examples of drug
-Mechanism
-Adverse effects
NRTIs
NNRTis
Protease Inhibitors

ART for HIV
-Examples of drug
-Mechanism
-Adverse effects
INSTIs
Fusion Inhibitor
CCR5 antagonist

HIV positive mothers should NOT
DO NOT breastfeed their infants
Polycythemia Vera
-def
-tends to occur after age
-SXS
-Workup
-Tx
-Complications

The most common cause of increased RBC production is
chronic hypoxia
Multiple Myeloma
-defined by
-abnormal monoclonal protein ___ produced by
-SXS
-Radiology
-Tx
-Complications

Lymphoma
-def
-categorized as
ALL is the
Most ALL originates in

Hodgkin lymphoma vs Non Hodgkin Lymphoma
cells of origin
classification low to higher grade
RF, patient population
SXS
Labs
Tx
Prognosis

Leukemia
-defined as
-acute leukemia tends to involve
-Bone marrow involvement can cause

ALL
-epidemiology
-def
-SXS
-Workup

ALL
-Blood smear
-Tx
-Complications

AML
-def
-SXS
-Workup
Blood smear
-Tx
-Complications

CLL
-def
-SXS
-Workup
-Blood Smear
-Tx
Complications

lymphoma

ALL